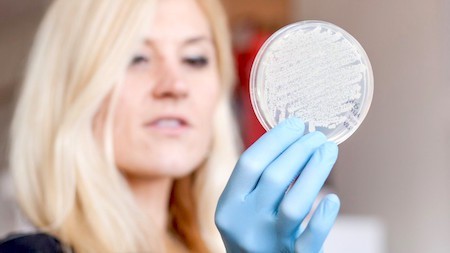

Marc Abrahams's Blog, page 308
September 12, 2015
Computerised gender classification (part 2, shoes etc)
The previous article in this series drew attention to the possibilities offered by eyebrows in the field of automated computerised gender classification. But eyebrows are by no means the only choice available to classifiers. For a recent (2015) roundup of the options on offer, see the work of Yingxiao Wu, Yan Zhuang, Xi Long, and Feng Lin, ‘Human Gender Classification: A Review’ (in: IEEE Sensors Journal, epub 2015)
 The team first outline the importance of the field:
The team first outline the importance of the field:
“The aim of gender classification is to recognize the gender of a person based on the characteristics differentiating between masculinity and femininity. It is considered as the one of the most important application [sic] using pattern recognition method in the area of artificial intelligence.”
And then go on to list the currently documented possibilities. [See diag. above] They include: body, eyebrow, handshape, fingernail, gait, gesture, hairstyle, footwear, voice, blogging style etc etc.

September 11, 2015
Snake Bites a Frequently-Metaphorical Snake
We reproduce only a portion of the image for this medical report. To see the full image, follow the link to the NEJM site.
“A Viper Bite,” Tajamul Hussain and Rafi A. Jan, New England Journal of Medicine [NEJM], vol. 373, no. 11, September 10, 2015. The authors, at Sher-i-Kashmir Institute of Medical Sciences, Srinagar, India, report:
“A 46-year-old farmer presented to the emergency department 3 hours after his penis was bitten by a snake while he was urinating in an open field. The snake was identified by the patient as “gunas,” which is the local name of the Levantine viper (Macrovipera lebetina). Physical examination revealed stable vital signs, with a grossly swollen penis and formation of hemorrhagic bullae at the puncture sites (Panel A)…. At 36 hours after the initiation of treatment, the patient’s coagulopathy had resolved and he was discharged home. The swelling subsided 4 days after discharge, with the formation of necrotic tissue at the puncture sites (Panel B). The patient had recovered completely at 2-week follow-up.”

Computerised gender classification (part 1: eyebrows)
Can you tell a person’s gender from just a glimpse of their eyebrows? Could a computerised system do the same? To find out, a project was undertaken by Yujie Dong (of the Holcombe Department of Electrical and Computer Engineering, Clemson University) and Damon L. Woodard (now at the Biometrics and Pattern Recognition Lab, University of Florida) in 2011. The team used Minimum Distance Classifier (MD), Linear Discriminant Analysis Classifier (LDA) and Support Vector Machine Classifier (SVM) algorithms to extract eight eyebrow features from images (rectangularity, eccentricity, and isoperimetric quotient etc.) and were then able to determine a subject’s gender with an average accuracy of 96%
 Because of their comparatively robust demarcation, eyebrows, say the team, provide a more reliable method of gender classification when compared to other ‘periocular’ [around the eye] features such as skin wrinkles – especially when the images are non-ideal, or, as some describe them ‘in-the-wild’. See: ‘Eyebrow shape-based features for biometric recognition and gender classification: A feasibility study’ (in: Biometrics (IJCB), 2011 International Joint Conference on. IEEE, 2011, pp. 1–8.)
Because of their comparatively robust demarcation, eyebrows, say the team, provide a more reliable method of gender classification when compared to other ‘periocular’ [around the eye] features such as skin wrinkles – especially when the images are non-ideal, or, as some describe them ‘in-the-wild’. See: ‘Eyebrow shape-based features for biometric recognition and gender classification: A feasibility study’ (in: Biometrics (IJCB), 2011 International Joint Conference on. IEEE, 2011, pp. 1–8.)
Coming soon : Computerised gender classification (part 2)

Language of science: The Berry Phase begets the Belly Phase
“The Berry Phase” is not the only Berry phrase.
Quantum physics turns (in more than one sense) on a concept called “the Berry phase“. The phrase, and in a way the concept, has recently given rise to a name for a phenomenon that occurs in your stomach: “the belly phase“.
(Note for quibblers: Yes, quantum physics does apply everywhere, including your stomach. So yes, “the Berry phase” does indeed pertain to your stomach in particular, as well as quantum physics in general.)
One and the same person — Professor Sir Michael Berry, FRS — bears full responsibility for identifying the Berry phase, and substantial responsibility for, three decades later, naming the belly phase. This is the paper in which Berry birthed the Berry phase:
What is the Berry phase? The concept takes a bit of explaining, if you are not intimately familiar with modern physics. Here are explanations from several different people: “Berry’s Geometric Phase — Introductory Lecture“; “The Berry phase“; “What is an intuitive explanation of the Berry phase?”
What is the belly phase? A newly published paper, “Geometric Mixing, Peristalsis, and the Geometric Phase of the Stomach“, explains:
Mixing fluid in a container at low Reynolds number—in an inertialess environment—is not a trivial task. Reciprocating motions merely lead to cycles of mixing and unmixing, so continuous rotation, as used in many technological applications, would appear to be necessary. However, there is another solution: movement of the walls in a cyclical fashion to introduce a geometric phase.We show using journal-bearing flow as a model that such geometric mixing is a general tool for using deformable boundaries that return to the same position to mix fluid at low Reynolds number. We then simulate a biological example: we show that mixing in the stomach functions because of the “belly phase,” peristaltic movement of the walls in a cyclical fashion introduces a geometric phase that avoids unmixing….
We have shown that such a geometric phase—the “belly phase” [35]—may be found in the stomachs of animals where Re < 1.
[Footnote] 35. We are indebted to Michael Berry for this coinage.
Here is that paper:
Michael Berry is active in many fields of science. In the year 2000. he and fellow physicist Andre Geim were awarded an Ig Nobel Prize for physics, for using magnets to levitate a frog.
Michael Berry bears substantial responsibility, also for writing one of the shortest abstracts ever for a scientific paper:

September 10, 2015
The new opera about each and every species of life
A new opera, called “The Best Life“, will premiere next week — as part of the Twenty-Fifth 1st Annual Ig Nobel Prize Ceremony.
Here’s the story line of “The Best Life“, as explained in the program that will be handed to all 1100 audience members in Harvard’s Sanders Theatre:

IgBill — the program that will be handed out to audience members — includes all the words to the mini-opera “The Best Life”. You can download a PDF version of IgBill, by clicking on the image.
The story: It’s the day before the greatest competition ever held — a competition to choose which ONE of the millions of species of life is THE BEST LIFE. The competition will be televised live, everywhere, and the public is going nuts, eager to pay huge prices to watch. All the species of life — every single species, millions of them! — are going to be together, IN ONE ROOM, for the competition. By special arrangement with Sanders Theatre, all these species will assemble here, in the theater, during Act 2 of the opera. If you have an aisle seat, please mind your feet. Also by special arrangement with Sanders Theatre, all the lawyers who will deal with the consequences of Act 2 will assemble here in the theater during Act 3. If you have feet, please mind your feet.
LIVE WEBCAST: Watch the live webcast of the entire ceremony, including the mini-opera, on Thursday, September 17, 2015, at 6:00 pm (US eastern time) on the ceremony web page. (The webcast actually begins a little earlier, at 5:40 pm.)
[Tickets to attend the ceremony in person have been sold out for weeks. It’s possible that a few tickets will become available shortly before the ceremony. Those tickets would be sold exclusively by the Harvard Box Office.]
CAST: The opera stars Maria Ferrante (soprano), Scott Taylor (baritone), and Daniel Rosenberg (chemist), with a two-person single-species orchestra composed of Patrick Yacono and Dr. Thomas Michel and their instruments, and the All-Species Chorus (abetted in Act 3 by many of the scientists who are in the Ig Nobel Prize ceremony).

September 9, 2015
Luxuriant Flowing Hair Club (LFHCfS) Woman of the Year in beer breakthrough
Dr. Anne A. Madden, the , is part of the team that made a beer-related breakthrough in the study and manipulation of yeast. Dr. Madden is pictured here (in a photo by Lauren Nichols), examining yeast cultures:
Dr. Madden will make a special appearance next week in the Twenty Fifth 1st Annual Ig Nobel Prize ceremony. The ceremony will be webcast live.
North Carolina State University announced the beer breakthrough:
From the Lab Bench to the Beer Glass
When John Sheppard was asked to brew beer from wild yeast, he was skeptical. Humans, after all, have been brewing beer for millennia. If there were yeasts out there that could make a good pint, they would surely have been found years ago. But, it turns out, Sheppard proved himself wrong….
But Sheppard was willing to give it a shot, and so he reached out to [NC State biologist Robb] Dunn. The biologist, in turn, reached out to the people in his research group to see if they had any ideas. One of those researchers was Anne Madden.
Madden is a postdoctoral microbiologist affiliated with both Dunn’s lab at NC State and Noah Fierer’s lab at the University of Colorado. In her official capacity as a postdoc, she studies the microorganisms of the “built environment” – particularly, how insects and other arthropods introduce microorganisms to homes, workplaces and other buildings. She is, in other words, an expert on the microscopic organisms that live on insects…. [You can read the entire story on the NC State web site.]

Podcast 28: A look back at the 2013 Ig Nobel Prize winners (PART 1)
The effects of opera on heart transplant patients who are mice; whether people who think they are drunk also think they are attractive; whether and how dung beetles pay attention to the Milky Way; Gustano Pizzo’s machinery for capturing, packaging, and transmitting an airplane hijacker; and the experiment to see whether and where people could run on water — all these all turn up in this week’s Improbable Research podcast.
Click on the “Venetian blinds” icon — at the lower right corner here — to select whichever week’s episode you want to hear:
SUBSCRIBE on Play.it, iTunes, or Spotify to get a new episode every week, free.
This week, Marc Abrahams tells about:
The 2013 Ig Nobel Prize winners – PART 1. (List of the 2013 Ig Nobel Prize winners, with links to their research. Featuring a dramatic reading by Jean Berko Gleason.) Here’s Gustano Pizzo’s Ig Nobel Prize-winning patent for a method to trap airplane hijackers:

The 25th First Annual Ig Nobel Prize ceremony (and webcast), which will happen on Thursday, September 17, 2015.
The mysterious John Schedler perhaps did the sound engineering this week.
The Improbable Research podcast is all about research that makes people LAUGH, then THINK — real research, about anything and everything, from everywhere —research that may be good or bad, important or trivial, valuable or worthless. CBS distributes it, both on the new CBS Play.it web site, and on iTunes and Spotify).

September 8, 2015
Could stegosaurs swim?
You might think, as many might have, that by virtue of the characteristic rows of heavy plates along their back and the spiny terminations of their tail, stegosaurs (and other armoured osteoderms) probably would have encountered considerable problems if they attempted to swim. Or did they? A new paper in PYGS : Proceedings of the Yorkshire Geological Society, v. 60, no. 3, pp. 227-233, May 2015, authored by Dr. Mike Romano and the late Dr. Martin Whyte, of the Department of Geography at the University of Sheffield, UK throws a new light on the question.
Their hypothesis is based around recently discovered geological evidence found at the Middle Jurassic (Ravenscar Group) of the Cleveland Basin of Yorkshire, UK – in the form of footprints. The authors suggest that a swimming stegosaur could well have dragged or paddled its feet through muddy river sediment as it swam – leaving impressions for us to contemplate some 150 million years later. They provide substantial evidence, with photos and artist’s illustrations, in : ‘Could stegosaurs swim? Suggestive evidence from the Middle Jurassic tracksite of the Cleveland Basin, Yorkshire, UK’
Also see: What is your favorite dinosaur, and why?

September 7, 2015
Celebrating Norway’s Ig Nobel Prize winners, and others, too
The Schrödingers katt science TV program celebrated some of Norway’s Ig Nobel Prize winners — and several other Ig Nobel Prize winners, too. They also interviewed me. Click on the image below, to be whisked to the Schrödingers katt web site and watch the entire episode:
The featured Norwegian winners include:
The 2014 Ig Nobel Prize for arctic science, awarded to Eigil Reimers and Sindre Eftestøl , for testing how reindeer react to seeing humans who are disguised as polar bears.
The 1999 Ig Nobel Prize for medicine, awarded to Dr. Arvid Vatle [whom you see in the image above, with Schrödingers katt presenter Solveig Hareide] of Stord, Norway, for carefully collecting, classifying, and contemplating which kinds of containers his patients chose when submitting urine samples.
The 1996 Ig Nobel Prize for medicine, awarded to Anders Barheim and Hogne Sandvik of the University of Bergen, Norway, for their tasty and tasteful report, “Effect of Ale, Garlic, and Soured Cream on the Appetite of Leeches“.
The bits with me, about the history of the ceremony, and how things work, are in four parts, interspersed with everything else in the program. Here are links to Part 1, Part 2, Part 3, and Part 4.
BONUS (possibly unrelated): CBC News reports on a kind of urine-collection vessel that is not included in Dr. Arvid Vatle’s Ig Nobel-prize-winning report: “Jerry Bance, Conservative caught peeing in mug, no longer candidate, party says“.

September 6, 2015
What else does that performing chemist perform?
You may have seen Daniel Rosenberg performing as a performing chemist in the Ig Nobel Prize ceremonies, and wondered, “What does this person do when he is not performing as a performing chemist in the Ig Nobel Prize ceremonies?” Mike Szczys answers that question, writing on the Hackaday web site:
DEMONSTRATING SCIENCE AT HARVARD UNIVERSITY
What if there was a job where you built, serviced, and prepared science demonstrations? This means showing off everything from principles of physics, to electronic theory, to chemistry and biology. Would you grab onto that job with both hands and never let go? That was my reaction when I met [Dan Rosenberg] who is a Science Lecture Demonstrator at Harvard University. He gave me a tour of the Science Center, as well as a behind the scenes look at some of the apparatus he works with and has built….
Here’s Daniel in action on the job, and in a video teaser for last year[2014]’s Ig Nobel ceremony:
At this year’s Ig Nobel Prize ceremony — the Twenty-Fifth 1st Annual Ig Nobel Prize ceremony, Daniel will also be one of the leads (Maria Ferrante and Scott Taylor are the other leads) in the new Ig Nobel mini-opera, “The Best Life”. Watch him on the ceremony live webcast.

Marc Abrahams's Blog
- Marc Abrahams's profile
- 14 followers